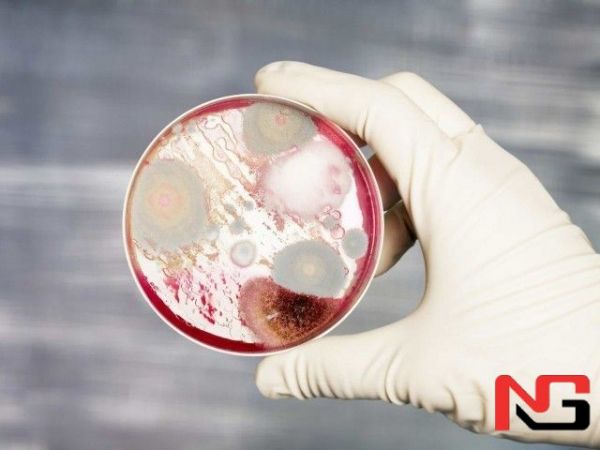
Қозоғистонда ўлган мол гўштини еганлар хавфли касалликка чалинди

Қозоғистон шимолида куйдирги эпидемияси қайд этилди. Натижада 10 киши касалхонага ётқизилган. Бу ҳақда Оқмўла вилояти ветеринария бошқармаси матбуот хизмати хабар берди.
Билдирилишича, ҳодиса Жарқайн тумани Ушкарасу қишлоғида содир бўлган. Маҳаллий иқтисодиётда жами ҳисобда 37 бош қорамол ушбу касалдан нобуд бўлган. Уларнинг гўшти эса қишлоқ аҳолисига тарқатилган. Натижада 12 киши куйдирги касалигига чалинган деб гумон қилиниб, шифохонага ётқизилган. Уларнинг ўнтасида ташхис тасдиқланган.
Беморларнинг барчаси ҳозир Эсил вилоят шифохонасининг юқумли касалликлар бўлимига жойлаштирилган. Бундан ташқари, мутахассислар беморлар билан алоқада бўлган 22 нафар шахсни аниқлади.
Маълумот учун, ушбу касаллик билан оғриган деб гумон қилинган ҳайвонни сўйиш оқибатида капсула ҳолатидаги микроб кислородли муҳитга чиқади ва жуда чидамли спора ҳосил қилади. У тупроқда 100 йилгача сақланиши мумкин. Одамларда эса тана ҳароратининг 41-42 даражагача кўтирилиши, нафас олиш ва юрак уришининг тезлашиши, ҳолсизлик, иштаҳа йўқолиши, шунингдек, ошқозон-ичак органлари фаолиятининг бузилиши ва қон кетиши каби асоратлар билан кечади.

Тасодифий хабарлар
Маст фуқаролар билан алоҳида ишланади
Метронинг “Космонавтлар” бекатида ёнғин содир бўлгани айтилмоқда
Ўйинчоқ тўппонча билан банкни ўмармоқчи бўлган ўзбекистонликка ҳукм ўқилди
Коронавируснинг энг ёш қурбони
ОАВ фаолиятига цензура ўрнатиш учун жавобгарлик кучайтирилади – Мирзиёев